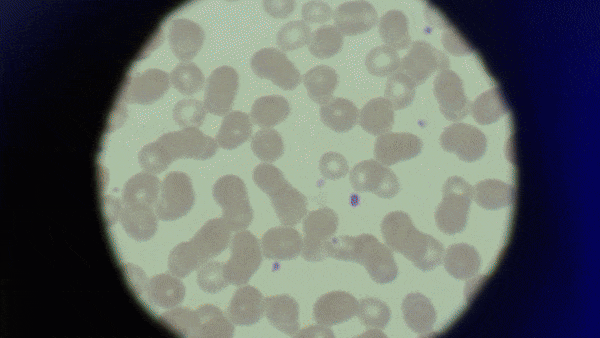

New York’s Eclectic Energy Landscape
Con Edison’s Energy Edficiency and Demand Management program comprises a wide variety of initiatives aimed and making New York a cleaner and more sustainable city. At the same time, managing this cross-section of independent departments and communications was proving very difficult.
The solution was an overarching campaign that rallied all the different initiatives under a single visual identity, clearly identifying the program to drive awareness and recognition. From benefit highlights to providing to context for Con Edison’s offering within the wider EEDM ecosystem of New York, the campaign leverages a range of visual and messaging elements that allow for visual flexibility and variation to stay relevant over time.








3D NYC Buildings








3D NYC Buildings






Social & Display